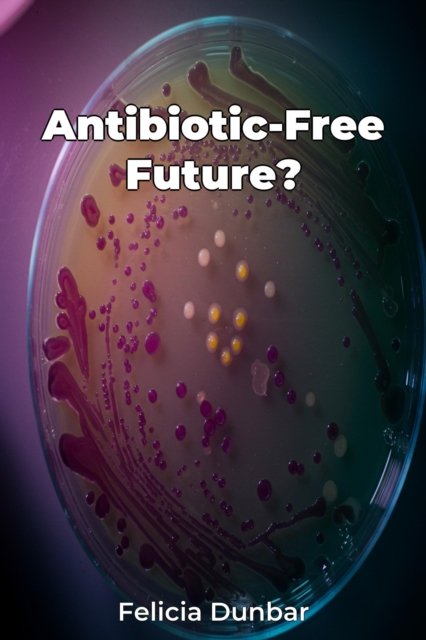
Antibiotic-Free Future?

Antibiotic-Free Future?
The escalating crisis of antibiotic resistance forms the central theme of "Antibiotic-Free Future?", which investigates the urgent need for innovative strategies to combat bacterial infections. Highlighting the potential return to a pre-antibiotic era, this book examines how common infections could once again become life-threatening due to the ineffectiveness of current treatments.
Did you know tha...
The escalating crisis of antibiotic resistance forms the central theme of "Antibiotic-Free Future?", which investigates the urgent need for innovative strategies to combat bacterial infections. Highlighting the potential return to a pre-antibiotic era, this book examines how common infections could once again become life-threatening due to the ineffectiveness of current treatments.
Did you know tha...
